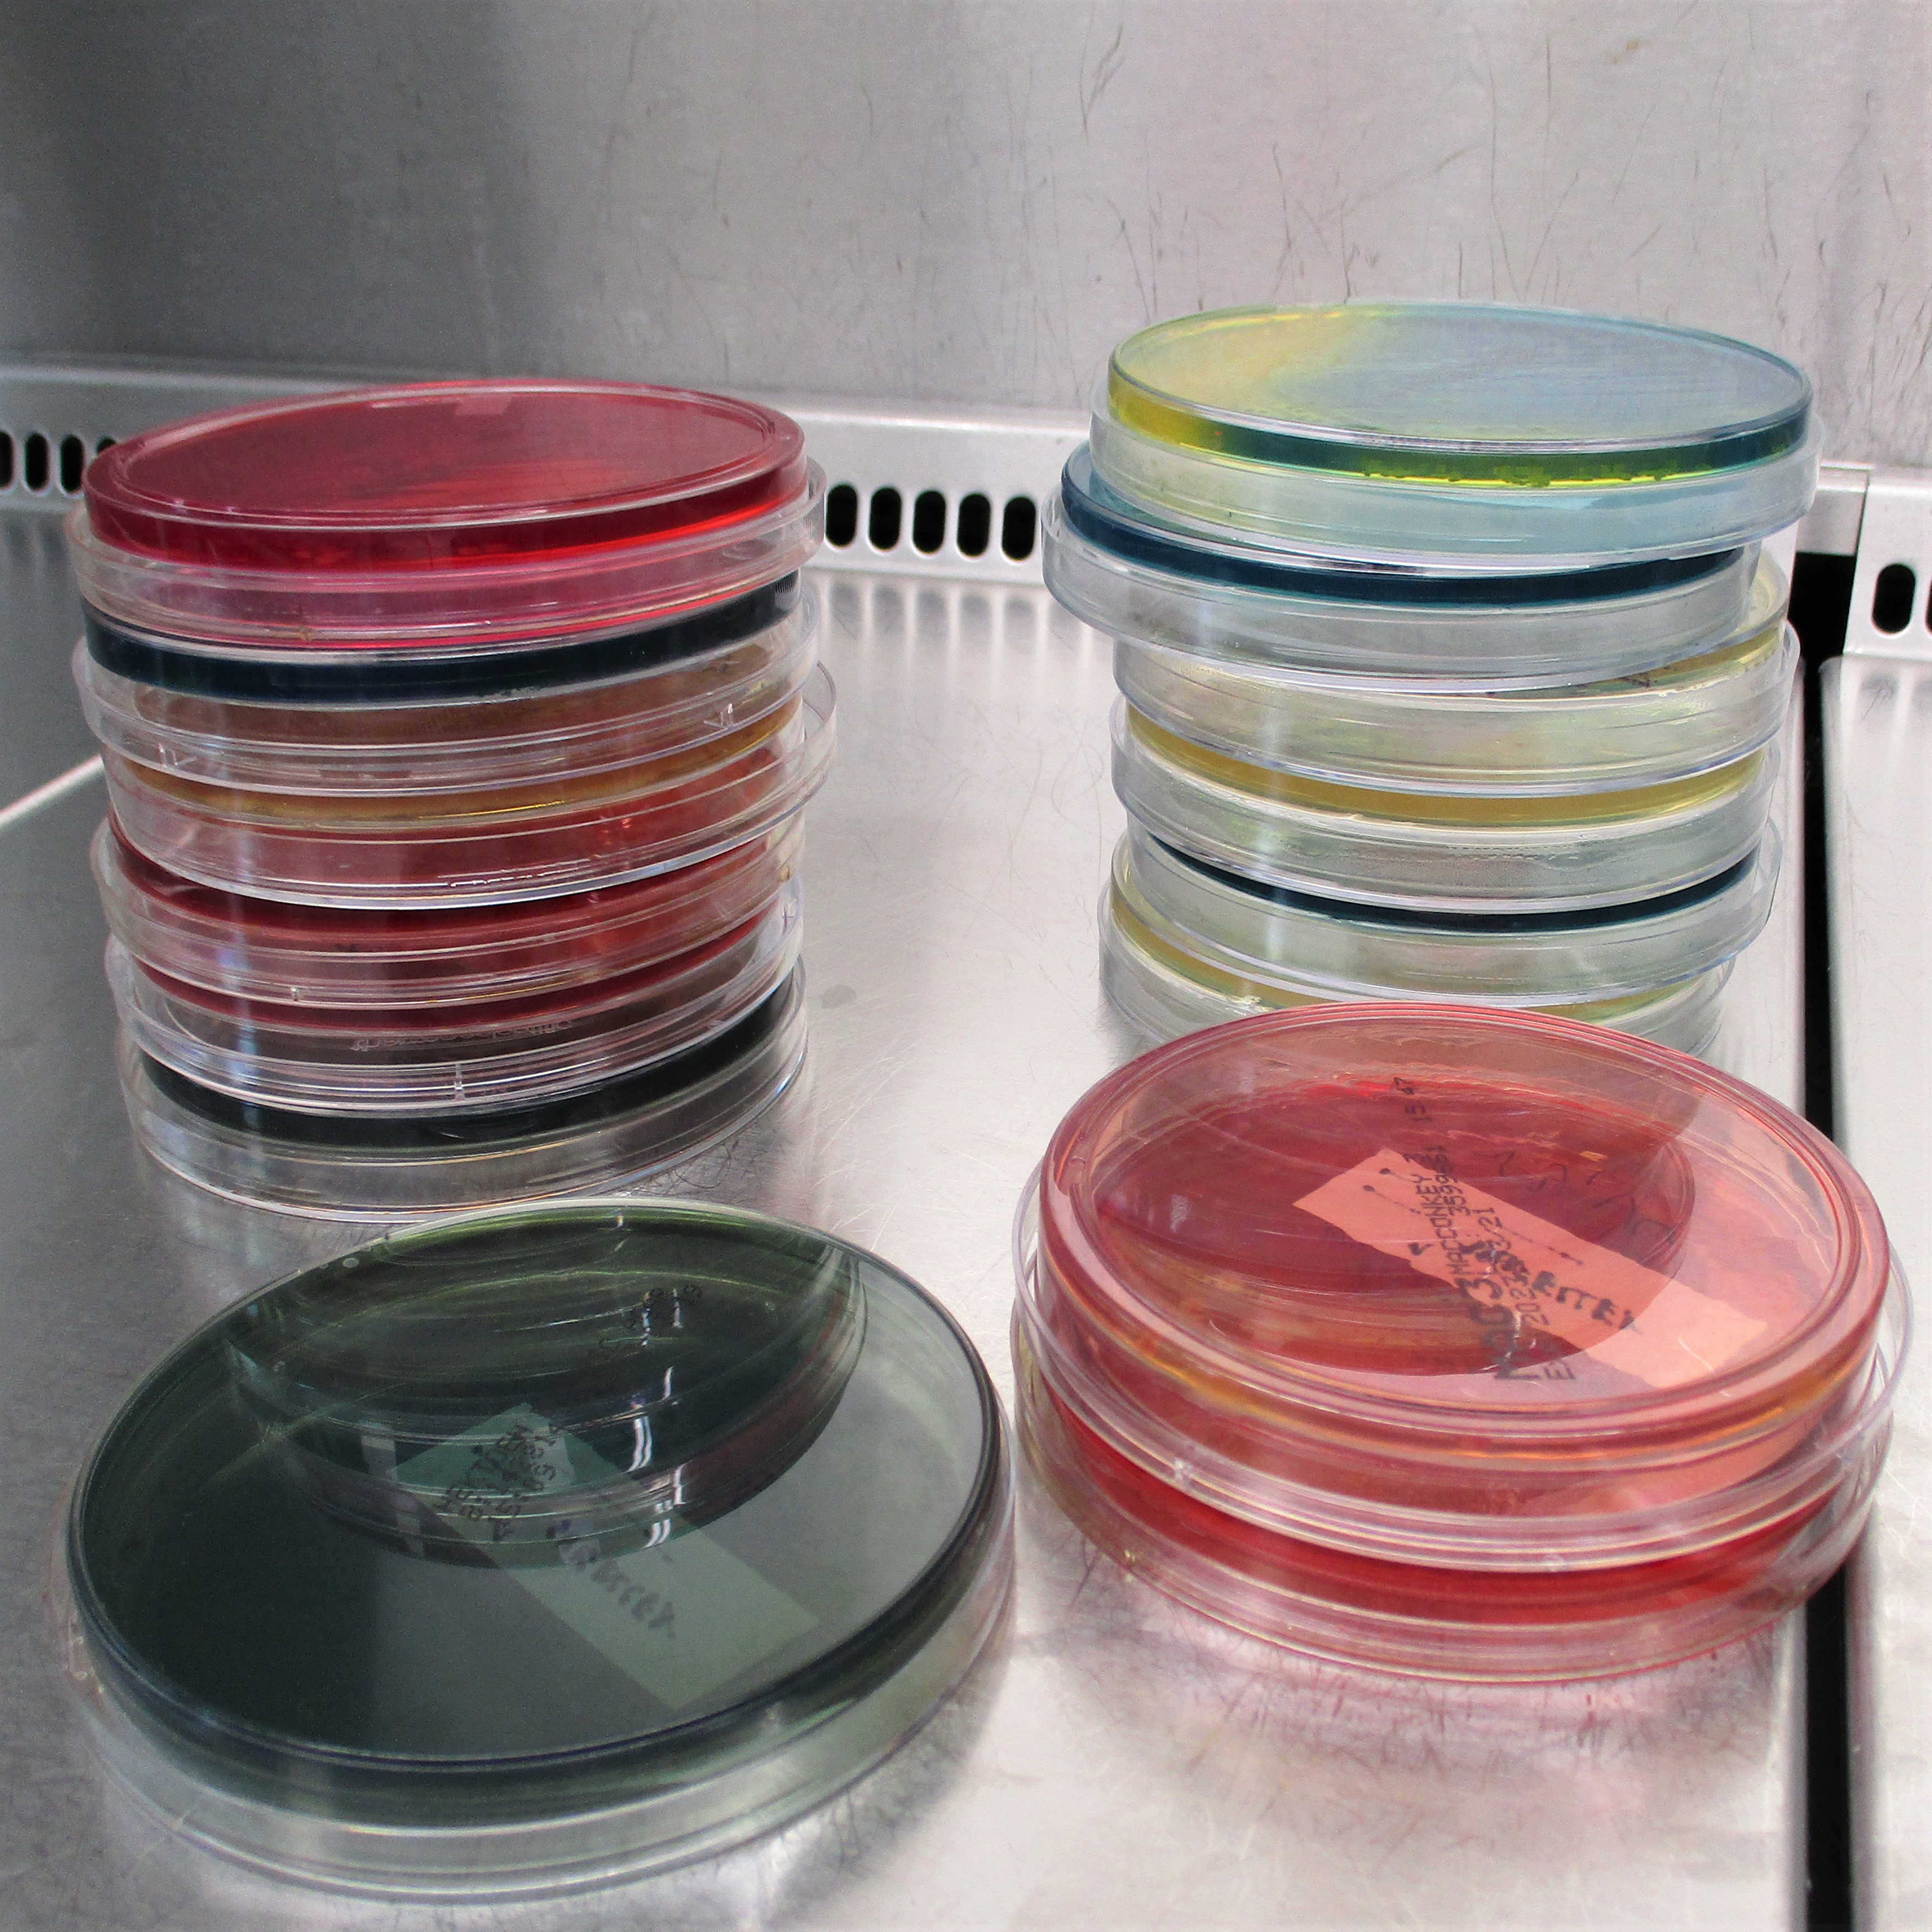
Platten Glass Cylinder

Publication Date
Publication Topic
31 results found

Automated DNA Extraction for Clubroot & Aphanomyces Testing in Canada
In a recent Seed World Canada article, Annu Albert describes how our Canadian labs use robotic DNA extraction to deliver fast, accurate clubroot and Aphanomyces soil testing for growers, seed producers, and infrastructure projects.
Read more
Essential Seed Testing for Your Spring Crops
In a recent article in Seed World Canada, Crop Science Business Development Manager Holly Gelech discussed how her team supports local growers.
Read more
Enhanced Soil Sample Testing Capacity Now Available in Taunusstein
Find out about high-quality testing through the latest state-of-the-art soil sample facility.
Read more
Crop Science Service Portfolio is Expanding in Spain
Our new experimental station for Crop Science is based in Benacazón, Seville. Situated in the heart of Spanish agriculture, it's fully equipped with for a range of crop-focused experiments.

SGS and AgriCircle Collaborate to Provide Joint Soil Health and Regenerative Agriculture Offering
Find out how SGS has collaborated with AgriCircle to provide soil health measurement solutions for regenerative farming practices.
Read more
Agro Soil Testing and Calculation Now Available for Carbon Sequestration - an SGS and Climate Neutral Group Collaboration
Find out how SGS and Climate Neutral Group are helping farmers shift to carbon farming practices.
Read more
Greenhouse and growth chamber capacities for special study designs at SGS in Emstek, Germany
The SGS Center of Agriculture Testing provides capacities for unique all-season test designs under protected and controlled conditions. Our experts support our customers with their long-lasting knowledge in study design and monitoring.
Read more
SGS’s Hamburg Lab Introduces GLP Five-Batch Analysis to Support the Biopesticide Industry
SGS has successfully run a GLP study on five-batch analysis for biological plant protection products at its dedicated biopesticide lab in Hamburg, Germany.
Read more
SGS To Expand Its Plant Genotyping Services to Brookings, USA
From October 2022, SGS's Brookings laboratory in South Dakota will provide key plant genotyping services.

DNA Screening and Comprehensive Microbiome Analysis for New Agricultural Products
SGS can now analyze the impact of biostimulants, pesticides and seed treatment solutions on the soil microbiome community.